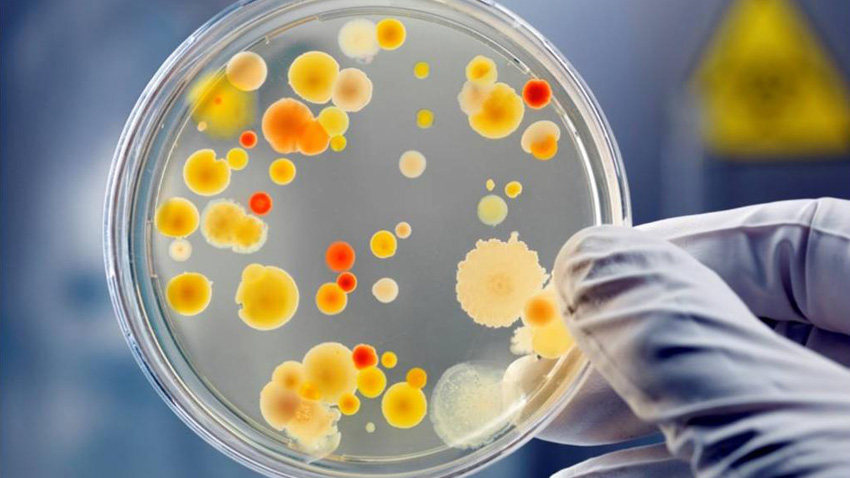

NANOTECNOLOGIA, RECUBRIMIENTOS & ADITIVOS


✔ Procedimientos estandarizados de medición de bacterias y hongos ambientales
✔ Mejoramiento de la calidad de aire a través de muestreo microbiológico, limpieza y desinfección
✔ Procedimientos de eliminación de microorganismos ambientales
✔ Soluciones y productos amigables para aplicación electrostática
✔ Muestreos pre y post desinfección